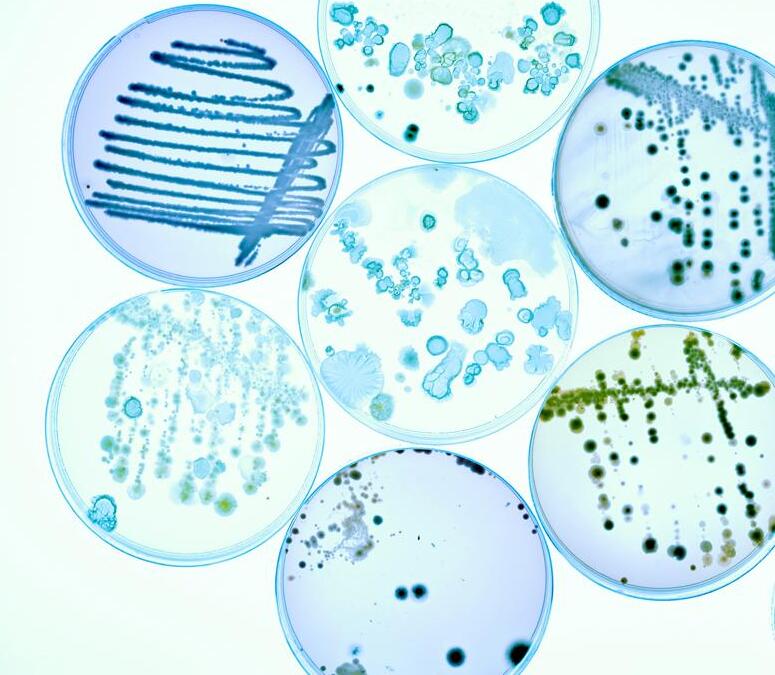

INVESTING ROUND THE WORLD
How to do it and the markets which matter








•
•
•
•
•















•
•
•
•
•






By
Afteradecentshowingin2022,theUK Thestockmarkethasfailedtofirein2023. goodnewsforinvestorsisshares inotherpartsoftheworldhavedone muchbetterandithasneverbeeneasiertohavea globallydiversifiedportfolio. instrumentsThereisanexcellentrangeofproductsand whichallowyoutoparticipateinthe returnsfrommarketsacrosstheglobeand,inthis article,weprovideasnapshotofthesedifferent options.AndifyouthinkUKstocksarelooking undervaluedafteryearsofunderperformance,we providesomeinsightsintohowtoplaythemtoo.

USstockmarketsgiveinvestorsaccesstooneofthe deepestandmostliquidcapitalmarketswhichare hometotheworld’slargestandmostsuccessful companies. exposureInvestinginUScompaniesmeansgettingtoaneconomywhichhasproventobe

How to do it through funds and a snapshot of the markets which really matter to investors
nameTheSPACissettorelistundernew purchaseasitcompletes$1billion ofassetsinBrazil

R etailinvestorsarebeingofferedthe bychancetobuysharesinafundraising produceaUK-listedminingoutfitlookingto metalsforelectricvehicles.ACGAcquisitionCompany(ACG)waslaunchedinOctober2022asaSPAC(specialpurpose acquisitioncompany)otherwiseknownasacash apartshell.Thesearelistedvehicleswhichhavenoassets fromcashandaresetupwiththeintentiontobuybusinessesorassets. agreeingACGhasfoundwhatitwantstopurchase,topay$1billionfortwoBrazilianmines. TheseareanickelsulphideassetcalledSantaRita, aoperatedbyacompanycalledAtlanticNickel,and bothproducingcopperminecalledSerrote.Theyare equitycurrentlyownedbyresources-focusedprivate OncefirmAppianCapital.thisdealcompleteACGwillchangeits raisenametoACGElectricMetalsanditislookingto $301milliontohelpcoverthecostsofthedealfromretailandinstitutionalinvestors. someTheremainderofthemoneyiscomingfrom heavyweightbackerslikeGlencore(GLEN) carmakerStellantis(STLA:NYSE)andspecialist mininginvestorLaMancha,eachofwhichhave aagreedtosubscribefor$100million,aswellas $100millionprepaymentforproductionfrom Volkswagen’s(VOW3:ETR)batteryventure PowerCo,somedebtandaroyaltyagreementwith RoyalGold(RGLD:NASDAQ) refinedTheplanisforthenickelconcentratetobeatGlencore’sfacilitiesinEuropeandNorth

intoAmericawiththefinalproductbeingincorporated electricvehiclebatteriesbyStellantis,PowerCoandothermanufacturers. forRetailinvestorshaveuntil18Julytosubscribe theretheshareoffer.Thoughbeforetheydo assetsissomesalientbackgroundtothese considering.andthewholeventurewhichisworth Theassetsinquestionwereintheprocess ofbeingboughtbySouthAfricanmininggiant Sibanye-Stillwater(SBSW:NYSE)beforeitpulledtheplugona$1billioncashdeal(witha5% aroyaltyonfutureoutput)inearly2022thanksto to‘geotechnicalincident’atSantaRita,thought miningbecrackswhichoccurredduringtheopenpit Appianoperation.disputedthiswasamajoradverseeventwhichjustifiedcancellingthetransactionand thebeganlegalproceedingsfora$1.2billionclaimin subjectHighCourtinLondon.AtlanticNickelisitself tolitigationinAustraliafromQueensland’s triedMiningStandardsInternationalwhichpreviously ACGtobuytheSantaRitamine.wassetupbyArtemVolynets,formerCEO theofsanctionedRussianaluminiumfirmEN+,listedin goldUKuntiltheinvasionofUkraine,andsmallcap minerChaaratGold(CGH:AIM)
Asset-backed stocks
Discover the shares which are trading at a discount to the value of their property and equipment
Did you know that we publish daily news stories on our website as bonus content? These articles do not appear in the magazine so make sure you keep abreast of market activities by visiting our website on a regular basis.
Over the past week we’ve written a variety of news stories online that do not appear in this magazine, including:

Theconsensusispricinginaashallow singledigitdeclineincompanyearnings beforeastrongfinalquarterrebound
Athesmarketsmoveintothesummerperiod everUSeconomyappearsasresilientas upcomingwhichputsgreaterfocusonthe earningsseasonwhichkicks- offon13July.
TheJunenon-farmpayrollsreport(7July)came inweakerthanexpectedforthefirsttimeinmore thanayearwith209,000jobsaddedcompared withconsensusforecastsof225,000.Inaddition, AprilandMaywasreviseddownbyacombined 110,000.However,unemploymentremainsatmultidecadelowsandmoreworryinglyfortheFederal Reserve,wagegrowthcameinhigherthan expectedandremainselevatedatanannualised rateof4.4%.TobeconsistentwiththeFed’s2%inflationtarget theconsensusviewisthatwagegrowthneedsto dropbyanotherpercentagepointto3.5%. pricingAftertheFedpausedinJune,marketsare ina92.4%chanceoftheFedhikingrates byaquarterofapercentagepointwhenitnext meetson26Julyanda72%chanceofahikein September,accordingtoderivativesplatformCME’s FedWatchtool. wasAswewriteJune’sconsumerpriceindexdata settobereleased.Theconsensusexpectation forcoreCPIwhichexcludesvolatilefoodandfuel
Thepricesisforadropfrom5.3%to5%yearonyear. followingweekretailsalesforJuneareduetobereleasedon18July. seasonThebigbankstraditionallykick-offtheearnings butthistimearoundPepsiCo(PRP:NYSE) andDeltaAirLines(DAL:NYSE)areduetoreport pre-marketon13July. JPMorganChase&Co(JPM:NYSE) Citigroup (C:NYSE)andWellsFargo(WFC:NYSE)and BlackRock(BLK:NYSE)reporton14July. lendingInvestorswillbelookingforsignsofstricter practicesfollowingthemini-bankingcrisis inthespringset-offbythefailureof[bold]Silicon Valleybank. 500ConsensussecondquarterearningsfortheS&P areforecasttodeclineby7.2%comparedwithayearago,whichwouldbethelargestdecline sincethesecondquarterof2020(31.6%)accordingtoFactSet positivelyInterestingly,morecompanieshaveguided comingintotheearningsseasonthanis usuallythecase.Theinformationtechnologyand industrialssectorsaccountformorethanhalfof toallfirmsissuingpositiveguidanceaccording reboundLookingFactSet.furtheraheadanalystsareprojectinga forS&Pearningsinthesecondhalfwhich,ifitturnsouttobethecasemeansthesecond quarterwillrepresenttroughearnings. Thirdandfourthquarterearningsareforecast togrowby0.3%and7.3%respectively,pushing calendar2023intopositiveterritoryby0.8%.[MG]
Wall Street faces a key test as companies get ready to report their second quarter numbers
Why Liberum believes the UK market is ‘ready to bounce’

Coca-Cola HBC pops 5% as strong summer start prompts 2023 profit upgrade
Warren Buffett’s 10 longest held stocks; how many do you own?

Capital at risk.
That’s the sweet sound of taking control of your investments with AJ Bell.





prices is for a drop from 5.3% to 5% year on year. The following week retail sales for June are due to be unveiled on 18 July.

As markets move into the summer period the US economy appears as resilient as ever which puts greater focus on the upcoming earnings season which kicksoff on 13 July.

The June non-farm payrolls report (7 July) came in weaker than expected for the first time in more than a year with 209,000 jobs added compared with consensus forecasts of 225,000. In addition, April and May was revised down by a combined 110,000.
However, unemployment remains at multidecade lows and more worryingly for the Federal Reserve, wage growth came in higher than expected and remains elevated at an annualised rate of 4.4%.
To be consistent with the Fed’s 2% inflation target the consensus view is that wage growth needs to drop by another percentage point to 3.5%.
After the Fed paused in June, markets are pricing in a 92.4% chance of the Fed hiking rates by a quarter of a percentage point when it next meets on 26 July and a 72% chance of a hike in September, according to derivatives platform CME’s FedWatch tool.
As we write June’s consumer price index data was set to be released. The consensus expectation for core CPI which excludes volatile food and fuel
The big banks traditionally kick-off the earnings season but this time around PepsiCo (PRP:NYSE) and Delta Air Lines (DAL:NYSE) are due to report pre-market on 13 July.






JPMorgan Chase (JPM:NYSE), Citigroup (C:NYSE) and Wells Fargo (WFC:NYSE) and BlackRock (BLK:NYSE) report on 14 July.

Investors will be looking for signs of stricter lending practices following the mini-banking crisis in the spring set off by the failure of Silicon Valley Bank.

Consensus second quarter earnings for the S&P 500 are forecast to decline by 7.2% compared with a year ago, which would be the largest decline since the second quarter of 2020 (31.6%) according to FactSet.
Interestingly, more companies have guided positively coming into the earnings season than is usually the case. The information technology and industrials sectors account for more than half of all firms issuing positive guidance according to FactSet.

Looking further ahead analysts are projecting a rebound for S&P earnings in the second half which, if it turns out to be the case means the second quarter will represent trough earnings.

Third and fourth quarter earnings are forecast to grow by 0.3% and 7.3% respectively, pushing calendar 2023 into positive territory by 0.8%. [MG]

When the big US companies are set to report
Analysts at Morgan Stanley turn cautious on UK lenders as rates set to stay high
Anyone following UK financial stocks must have wondered what on earth was so awful about the latest trading update from OSB (OSB) that the shares lost almost a third of their value in a single day last week.
The answer is a sudden but we suspect longoverdue admission that higher interest rates aren’t a cure-all for bank profitability, and borrowers are responding much faster than expected to competition in the mortgage market.
In its statement, released after the market closed last Thursday, the ‘challenger’ bank – which own the Kent Reliance, Charter Savings Bank and Precise Mortgage brands – reported it had seen a ‘step change’ in the behaviour of customers at its mortgage business as they reached the end of their initial fixed term.
Rather than suck up higher rates on new loans, it seems owner-occupiers and buy-to-let borrowers are refinancing much earlier than normal so they spend less time on the higher reversion rate.
As a result, OSB revealed it had to take a significant impairment charge as it adjusted the carrying value of the loan book downward to reflect a lower level of future net interest income.

The bank said it required ‘significant judgement in estimating how long customers will spend on the higher reversion rate in the future’ but it now expected borrowers to spend an average of just five months on the reversion rate meaning it needed to take a first-half charge of £160 million to £180 million for lost income.
At the same time, analysts at Morgan Stanley believe the flight from non-interest-bearing current and instant savings accounts to competitivelypriced fixed-term deposits could also take a big
chunk out of UK banks’ future earnings.
‘As interest rates overshoot, we believe there is an increasing risk that more deposits than previously anticipated move from non-interest bearing to interest bearing, causing the mix to deteriorate and pushing banks to further reduce the size of their structural hedge.’
Rather than the term deposit mix for what they call the ‘incumbent banks’ increasing from below 10% to over 20% in 2024, the team at Morgan Stanley believe greater competition and higher-for-longer interest rates mean the peak could be over 30%.
‘Our sensitivity analysis points to 10% to 13% earnings risk from a 5% increase in term deposits from non-interest bearing current/instant access accounts,’ they add.
As a result, they have taken a much more cautious stance on the prospects for three of the four big high-street lenders – Barclays (BARC), Lloyds Banking (LLOY) and NatWest (NWG) –as well as Virgin Money (VMUK). [IC]
Twitter rival hits the ground running but analysts urge caution over monetisation potential
The rival to Twitter launched by Meta Platforms’ (META:NASDAQ) – Threads – has become the fastest app ever to blast through the 100 million users mark. Having launched on 7 July, the new microblogging platform made the breakthrough in less than a week. By contrast, OpenAI’s ChatGPT, previously the fastest app to 100 million users, took about two months to get there earlier this year.
The Threads launch has been ‘way beyond our expectations,’ said Meta’s chief executive and founder Mark Zuckerberg.
Threads has many features in common with Elon Musk’s beleaguered Twitter, although not yet elements like hashtags and direct messaging. These similarities have prompted threats of legal action, although some legal experts have said copyright infringement could be almost impossible to prove.
Despite its rapid user growth, Threads still has some way to go to match the latter’s 300 million users. Threads is available in about 100 countries, including the UK, but not yet in the EU.

Twitter struggled for years to generate net profit,
Number of users per platform
100 million users
300 million users
turning a corner in 2018 and 2019, only to fall back into the red since. In 2022, Twitter reported a $221.4 million net loss on total revenue of $4.4 billion, a 12% decrease from 2021, made largely from advertising.
Wall Street analysts have downplayed Threads’ impact on Meta’s financials in the near-term given the company’s focus on user growth and not on monetisation, although analysts at Evercore ISI have argued that the new app ‘poses very little downside for Meta’s current business but creates revenue and profit upside optionality for the company’.
‘Over the next couple of years, we estimate Threads could potentially reach close to 200 million daily active users and generate $8 billion in annual revenue, or 5% upside to our current 2025 revenue estimate for Meta,’ said Evercore ISI in a note to clients.
‘Assuming 50% incremental margins, we estimate that $8 billion in Threads revenue would generate almost $1.50 in incremental EPS (earnings per share), or 6% to 7% accretion to Meta’s 2025 estimated EPS.’
But there are other concerns too, such as how it manages the regulatory environment, particularly around the thorny issue of user data privacy.
Mark Zuckerberg has pitched Threads as a ‘friendly’ refuge for public discourse online, framing it in sharp distinction to the more adversarial Twitter. ‘We are definitely focusing on kindness and making this a friendly place,’ said the Meta CEO shortly after the app’s launch.
But maintaining that idealistic vision for Threads is another story, and it will likely find itself eventually courting the same complaints about hate-speech, any number of ‘isms’, online stalking and other societal issues that still dog Twitter. [SF]
Can the online greetings card seller continue to prove it is no post-Covid loser?
Shares in Moonpig (MOON) have rallied 44% to 163.6p year-to-date with the online greetings cardsto-gifting platform delivering solid trading and avoiding the downgrades sceptical investors expected.
Shareholder excitement will be tempered by the fact the shares are trading more than 50% below their 350p, February 2021 initial public offering price.
One of the retail sector’s mostshorted stocks, investors were quick to write Moonpig off as a Covid winner and a post-pandemic loser,
so this year’s rally also likely reflects a short covering bounce.
Results (29 June) for the year to April 2023 demonstrated the resilience of the business, showing decent 5.2% sales growth to £320.1 million with reasonably robust margins and cash flow. Looking ahead to full year 2024, Moonpig expects mid-to high-single-digit revenue growth with all of its brands returning to growth in the second half
Canaccord Genuity’s Karl Burns remains bullish on what he regards as a quality, capital light and cash
Despite a rise in third-quarter organic sales investors want a better outlook
Technology products retailer Currys (CURY) has seen its share price crumble 14.9% year-to-date to 48.4p, a 10-year low, in the wake of poorly-received full-year results (6 July).
Not only did the white goods-toelectronics seller report a drop in sales and profits for the year ended 29 April 2023, it also passed the final dividend on a very cautious outlook for consumer spending to proactively protect the balance sheet.

Annual results showed group adjusted pre-tax profits of £119
million, towards the top end of guidance as cost-cutting helped drive earnings improvement in the UK and Ireland business. But this was down £73 million year-on-year due to lower profits in the Nordics, where falling consumer demand exacerbated by heavy competitor discounting brought Currys’ long-run record of Scandinavian success to an abrupt halt.
‘Our market has been tough everywhere, with depressed demand, high inflation and unforgiving competition,’ warned CEO Alex
generative business with high market share and ‘still with a long runway of structural growth’.
Doubts remain over Moonpig’s ability to deliver growth given a toughening consumer backdrop and the fading of the lockdown e-commerce boom, while the lingering leverage on the balance sheet, with net debt of £167.7 million at last count, is also cause for concern in a higher interest rate environment. [JC]
Baldock, adding that looking ahead, his charge is ‘wary of optimism about consumer spending power’.
The FTSE 250 retailer reported a substantial statutory loss of £450 million for the year, though this this was struck after a £511 million accounting charge relating to the 2014 merger of Dixons and Carphone that created the enlarged company, and didn’t represent cash going out of the business. [JC]
FULL-YEAR RESULTS
July 17: Northern Bear, Gore Street Energy Storage Fund
July 19: Redcentric
HALF-YEAR RESULTS
July 20: PensionBee, Howden Joinery
TRADING ANNOUNCEMENTS
July 14: Burberry, Mcbride, Ashmore, Liontrust Asset Management
July 18: IntegraFin, Rio Tinto
July 20: PensionBee, SSE, Dunelm, Diploma, QinetiQ
Leading kitchen supplier reported solid trading in April but the backdrop has deteriorated sharply
First-half results from Howden Joinery (HWDN) on 20 July will reveal the impact a slowdown in the housing market is having on its trading.
The trade kitchen supplier last updated in the spring, with a trading statement covering the 16-week period to 15 April. Like-for-like revenue was flat on the same period a year earlier in the UK business once you accounted for the impact of an additional sales day in 2022. However, since then there has been a big increase in gilt yields and the first evidence that a resulting rise in mortgage rates is having a tangible impact on house prices. Halifax reporting house prices fell at the fastest rate since 2011 in June –down 2.6%.
A slowdown in the market will probably be bad news for Howden as
less people will be on the move and looking to revamp the kitchen in their new homes. Pressures on household budgets as mortgage costs go up may also hit appetite for renovation projects and if housebuilders dial back on developments Howdens will lose out in its Contracts division, which serves this segment of the market. Investment bank Berenberg says: ‘While we are cautious on discretionary RMI (repair, maintenance and improvement) activity given tough Covid-19 comparatives and increasing pressure on the consumer, we think Howden will outperform its end markets.’

All eyes will be on global streaming platform’s Netflix (NFLX: NASDAQ)

subscriber numbers when the company reports second quarter earnings on 19 July.
The last set of subscriber additions, 1.75 million in the first three months of 2023, disappointed investors and caused its shares to fall 10% on the news.
Netflix’s shares have since recovered and are now trading around the $433 mark, up 135% over the past year.
There is more scope for positive or negative surprises on this metric as the company has stopped giving guidance on it.
Despite the downward spiral in
first-quarter subscriber numbers, Netflix has reaffirmed it is ‘on track’ to meet full year 2023 financial objectives, forecasting revenue of $8.2 billion up 3% year-on-year. Netflix also said it was going to launch a password-sharing crackdown starting with the US in May this year.

Analysts at US banking giant Goldman Sachs (GS:NYSE) believe if the US streaming services company can get this right then it can ‘grow its revenue by 55% to about $49 billion in 2025, as well as grow its 2025 GAAP earnings per share to the $22-$27 range’. Netflix earned $9.95 per share in 2022.
Goldman’s estimates are driven by the assumption that Netflix can convert 70 million of its estimated 100 million password sharers into full subscribers, either by adding another household to an account for $8 or via an ad-based subscription.
Additionally, Goldman expects Netflix to grow its core subscriber base by about 2%. [SG]
July 14: UnitedHealth, JPMorgan, Wells Fargo, BlackRock, Citigroup, State Street, LM Ericsson, July 17: Equity

Lifestyle, FB Financial, TomTom
July 18: Bank of America, Novartis, Morgan Stanley, Prologis, Charles Schwab, Goldman Sachs, PNC Financial, Bank of NY Mellon, Swedbank, Omnicom, JB Hunt, Steel Dynamics, Hancock Whitney, PacWest, Bank First National, Mercantile
July 19: Netflix, IBM, Elevance Health, US Bancorp, Haliburton, Equifax, Nasdaq, United Airlines Holdings, Texas Capital July 20: J&J, Abbott Labs, Philip Morris, Blackstone, Marsh McLennan, Infosys, American Airlines, Tenet Healthcare, Crocs, Scholastic
Investors will be pondering whether the streaming platform’s change in strategy is paying off



With all the hype around technology stocks, and AI (artificial intelligence) in particular, the UK life insurance sector is probably a long way down the list of investors’ priorities right now, yet for value players as well as income seekers there is plenty to like.
On one hand, the unrecognised value of the cash flows from their existing businesses could far outweigh their current valuations meaning substantial ‘hidden’ potential, while on the other dividend yields across the sector are on a par with inflation.
We think Phoenix (PHNX) is the stand-out, and believe the FTSE 100 player’s shares should be trading substantially ahead of their current level.
Berenberg analyst Thomas Bateman describes Phoenix, the UK’s largest consolidator of long-term savings and retirement plans, as ‘a cash machine’.
The current in-force book of policies generates £500 million per year in surplus capital, which the firm ploughs back into the ever-growing UK pension market acquiring back books from other insurers such as 2022’s deal to buy Sun Life UK.
At the end of December 2022, Phoenix reported in-force long-term free cash flow of £12.1 billion, which represents all the cash available to shareholders if the group decided to stop making acquisitions and simply let its existing policies run down.
By discounting all this future cash flow back to today Bateman estimates the net present value of the group is £8.7 billion, which he considers ‘extremely conservative’ but still compares very favourably with the firm’s current market value of around £5.3 billion.
‘Long-term free cash flow is a good proxy for the value of the company, and has become an even more important KPI (key performance indicator) since the management remuneration is tied to it;
Price: 527p
Market cap: £5.28 billion
the target implies growth between 20% and 27% over the next three years,’ says the analyst.
UK pensions are a structurally growing market, and Phoenix is exposed to positive trends in both DB (defined benefit) and DC (defined contribution) schemes.

Meanwhile, there are still plenty of opportunities to keep reinvesting excess capital at attractive margins.
‘Phoenix continues to search the UK heritage market for potential back-book acquisitions – the acquisition of Sun Life UK, which closed in April, represented £10 billion of AUM (assets under management), and there is still £470 billion in this market,’ observes Bateman.
Finally, thanks to its prodigious cash flow generation and £1.7 billion of ‘surplus’ solvency, Phoenix pays out more than 50p per share in annual dividends meaning at the current price it yields almost exactly 10% making it ideal for income-seekers as well as value investors. [IC]
With sector financing remaining tight the trust can use its flexible approach to support exciting companies
Since inception in October 2019 RTW Biotech Opportunities (RTW) has delivered 65.3% growth in NAV (net asset value), smashing the performance of the Russell 2000 Biotech index which is down 0.7% as well as the NBI (Nasdaq Biotech Index) which is up 20.6% over the same period.
Despite the superior performance to the benchmark and peers, the shares trade at an unwarranted 23% discount to NAV, representing a great chance to buy.
The NBI has endured the second largest ever correction in its history losing 70% from the post-pandemic peak which has created a big opportunity for specialist managers to exploit.
RTW is well placed to take advantage of the gloom and value in the biotech space having received (16 June) proceeds of $99.1 million related to Merck’s (MRK:NYSE) takeover of portfolio company Prometheus Biosciences. This represented a return of 11.8 times on its initial investment.
Part of the reason for the shares trading at a discount is that the name of the trust until 27 June was RTW Venture Fund suggesting it was a riskier biotech venture capital investor, which it is not.
Secondly, the sector is deeply out of favour as seen by the huge correction in the NBI in the last two years and funds often trade at a discount when sentiment is poor.
The name change should mean prospective investors START comparing the trust to wellknown peers Bellevue Healthcare Trust (BBH), International Biotechnology Trust (IBT) and Worldwide Healthcare Trust (WWH).
RTW is a full life cycle investor which means
(RTW) Price: $1.33 Market cap: £220 million
it can invest in different stages of a company’s development and has the flexibility to focus on the most attractive parts of the market. It is looking to identify next-generation therapies which can significantly improve patients lives. The investment in Prometheus, which is focused on treatments for diseases caused by abnormal activity of the body’s immune system, is a good example of the manager’s approach.
It co-led a private placing round in 2020 which raised $130 million then participated in the initial public offering in March 2021 and a further $500 million fundraise in December 2022.
The proceeds from the Prometheus exit will be used partly to address the discount to NAV where the company intends to conduct an ‘NAV-accretive’ share buyback of up to $10 million.
Given the attractive valuations on offer in biotech and increasing mergers and acquisitions, the board believes an ‘appropriate level’ of the proceeds should be invested into ‘highly attractive’ opportunities. [MG]
isn’t reflected in a wide
Executive chairman has built a robust company with a strong senior management team
£11.28
Loss to date: 12.6%
If the esteem in which investors hold an executive is measured by share price action on their departure news, Jet2’s (JET2:AIM) Philip Meeson could barely hold a higher reputation.
News that Meeson is planning his retirement saw the company’s share price plunge more than 10%, swiping around £250 million off Jet2’s market cap, and slammed Shares’ February 2023 Great Idea into the red.

As executive chairman and architect-in-chief of Jet2’s transformation from delivering flowers into the UK’s biggest package holidays company and third largest airline, Meeson has created enormous value for investors. Morningstar data shows 18.4% annualised total returns (share price gain/loss plus dividends) over the last decade versus a little more than 5% for the FTSE 100.
Meeson, a former RAF pilot and aerobatics champion and now aged 75, plans to stay on for a bit, to ensure an orderly handover. It is also worth noting that the airline already has a trusted senior management team with a proven strategy..
Full-year results to 31 March showed a strong recovery in revenue and profits, robust forward bookings and more than £1.1 billion of cash, excluding customer deposits. It has benefited from surging demand for air travel.
Investors are wondering if Meeson will start to sell down his 18.3% stake in the business. As Jet2’s largest shareholder by a mile, it is natural to expect someone stepping down, and at his age, to want to crystallise some of the gains he’s made over the years.
Shares suspects any disposal will be handled sensibly and that there will be no shortage of buyers to meet demand for Meeson’s shares should they become available. Which leads us to believe that Meeson’s planned departure is a short-term bump for the share price, and one that has simply created a better buying opportunity than existed a week ago. Still a buy for the long-term.
• The UK is a very international market with around half the revenues of UK-listed companies generated in the United States and Asia Pacific, with Europe also holding a major share.

• The UK market trades at an approximate 20% discount to global equities.
• The yield premium for the UK market is now at its highest point for the last 15 years.
It is some years since UK equity income portfolios were the toast of the town for the core of an investment portfolio. Investors have been seduced by the charms of global income portfolios. After all, why not have the whole world at your fingertips rather than just a single market? The reality is more nuanced.
The UK is an international market. Many companies listed on the UK market draw their sales from around the world, which means they are not dependent on the UK’s - admittedly sluggish - domestic economy. The United States and Asia form around half the revenues of UK companies, with Europe another significant chunk. Investors are already getting global income from their UK portfolios. But why not just buy a global income portfolio and get the broadest possible opportunity set? The answer lies in the valuations of UK companies, which have been pushed lower by weaker confidence in the UK economy and political system. This has left UK

share prices cheap relative to their global peers.
The absolute discount to global markets sits at around 35%. However, the UK market has lighter representation in areas such as technology, which tend to trade on higher valuations. Adjusted for these sector differences, our estimates suggest the UK market is at an approximate 20% discount to global equities.
We see this in the rating of UK companies relative to their international peers. A variety of companies in the Murray Income portfolio helps to highlight this: BP trades at a price to earnings ratio around 40% below US-listed Exxon; Diageo’s valuation is around two-thirds that of US distiller Brown Forman as is Rentokil compared to US peer Rollins; Smith & Nephew trades at around 16x its annual earnings, compared to 25x for US-listed competitor Stryker. It is difficult to determine differences in the operations and prospects for these businesses yet there is a chasm in terms of their valuations.
Apart from the global financial crisis, the UK’s market multiple is nearing its lowest point for 30 years. It is cheap
in absolute terms, relative to history and also relative to global equities. Investors are getting global income at a knock-down price by investing through the UK market.
The UK has a long-established and well-developed dividend culture. While other countries have improved their payouts to shareholders in recent years, few can match the track record of UK companies. The yield for the FTSE All Share is currently 3.7%, which puts it significantly ahead of most major markets. The S&P 500, for example, yields just 1.7%.
This premium has always existed, but is particularly high today as poor sentiment towards the UK has depressed share prices (yields are expressed as a percentage of the share price). The yield premium is now at its highest point for the last 15 years.
Equally, dividend cover looks healthier than it has for some time. The pandemic allowed many companies to re-set their dividends to more realistic levels. Aggregate dividend cover – the amount of profit a firm makes divided by the dividend it pays out – for the FTSE 100 is now
more than 2x, having been below 1.5x as recently as 2016.
It is also worth noting that UK investors in global equity income funds will usually see a drag from withholding tax. This lowers distributable income for overseaslisted investments, but has no bearing for investments in UK-listed companies.
The UK market is often seen as oldfashioned, stuffed with yesterday’s companies in mature, low-growth industries such as banking and fossil fuels. This may be true of the UK’s largest companies, but looking beyond the mega-caps, there is an increasing
range of companies exposed to exciting global themes, such as digitalisation, the energy transition and emerging global wealth.
Equally, where there are gaps, these are readily plugged. At Murray Income Trust, 20% of the portfolio can be held in overseas-listed companies. This allows us to fill any holes in our exposure or diversify risk in concentrated sectors. At the moment, that exposure includes high quality companies such as Microsoft (Artificial Intelligence), Kone (elevators), Novo Nordisk (diabetes and weight loss), Accton Technology (network equipment), LVMH (luxury goods), VAT Group (semiconductors) and L’Oreal (cosmetics).
In short, if Murray Income Trust were a global income fund focused on high quality businesses, it would look extremely similar to its current makeup. In achieving the aim of a high and growing income (Murray Income Trust is approaching 50 years of consecutive dividend growth) combined with capital growth, the UK market serves us very well.
Companies selected for illustrative purposes only to demonstrate the investment management style described herein, and not as an investment recommendation or indication of performance.
Important information:
Risk factors you should consider prior to investing:
• The value of investments, and the income from them, can go down as well as up and investors may get back less than the amount invested.
• Past performance is not a guide to future results.
• Investment in the Company may not be appropriate for investors who plan to withdraw their money within 5 years.
• The Company may borrow to finance further investment (gearing). The use of gearing is likely to lead to volatility in the Net Asset Value (NAV) meaning that any movement in the value of the company’s assets will result in a magnified movement in the NAV.
• The Company may accumulate investment positions which represent more than normal trading volumes which may make it difficult to realise investments and may lead to volatility in the market price of the Company’s shares.
• The Company may charge expenses to capital which may erode the capital value of the investment.
• Derivatives may be used, subject to restrictions set out for the Company, in order to manage risk and generate income. The market in derivatives can be volatile and there is a higher than average risk of loss.
• There is no guarantee that the market price of the Company’s shares will fully reflect their underlying Net Asset Value.
• A s with all stock exchange investments the value of the Company’s shares purchased will immediately fall by the difference between the buying and selling prices, the bid-offer spread. If trading volumes fall, the bidoffer spread can widen.
• Certain trusts may seek to invest in higher yielding securities such as bonds, which are subject to credit risk, market price risk and interest rate risk. Unlike income from a single bond, the level of income from an investment trust is not fixed and may fluctuate.
• Yields are estimated figures and may fluctuate, there are no guarantees that future dividends will match or exceed historic dividends and certain investors may be subject to further tax on dividends.
Issued by abrdn Fund Managers Limited, registered in England and Wales (740118) at 280 Bishopsgate, London EC2M 4AG. abrdn Investments Limited, registered in Scotland (No. 108419), 10 Queen’s Terrace, Aberdeen AB10 1XL. Both companies are authorised and regulated by the Financial Conduct Authority in the UK.
Find out more at www.murray-income.co.uk or by registering for updates. You can also follow us on social media: Twitter and LinkedIn

After a decent showing in 2022, the UK stock market has failed to fire in 2023. The good news for investors is shares in other parts of the world have done much better and it has never been easier to have a globally diversified portfolio. There is an excellent range of products and instruments which allow you to participate in the returns from markets across the globe and, in this article, we provide a snapshot of these different options. And if you think UK stocks are looking undervalued after years of underperformance, we provide some insights into how to play them too.

US stock markets give investors access to one of the deepest and most liquid capital markets which are home to the world’s largest and most successful companies.
Investing in US companies means getting exposure to an economy which has proven to be
very resilient, and dynamic. US companies derive 71% of their revenues domestically, one of the highest proportions among developed markets, according to Morgan Stanley.
Buying US stocks and bonds means getting exposure to the world’s reserve currency. The US dollar tends to benefit during times of economic stress as investors buy US treasuries for relative safety.
Although the US has had its fair share of stock scandals, US markets are well regulated with good investor protections and a strong rule of law.
US stock markets have delivered strong returns over the last few months, and over the last decade. Investors may have got ahead of themselves with sentiment running ahead of the fundamentals.
US markets are overvalued on several valuation metrics such as the cyclically adjusted PE (price to earnings) ratio which means they are vulnerable to a pull back as Shares recently highlighted
In other words, US markets are priced for perfection and do not factor in significant recession risks.
The benchmark US index is the S&P 500, comprised of the 500 largest companies by market capitalisation.
Investors looking for passive exposure could consider the iShares Core S&P 500 (CSP1) which has $45 billion in assets and total expense ratio of 0.07%.
The Nasdaq 100 index is comprised of a selection of non-financial firms listed on the Nasdaq exchange. It is often used to get exposure to the biggest technology companies. This can be tracked through the Lyxor Nasdaq 100 (NASL) which has
$1.4 billion of assets and ongoing charges of 0.22% a year.
The £4.2 billion JP Morgan Equity Income Fund (B3FJQ59) invests exclusively in large attractively valued dividend paying stocks that are expected to continue growing their dividends.
The stocks are selected by a highly experienced investment team leveraging fundamental insights from more than 20 US-based equity research analysts.
The fund has a trailing dividend yield of 2.5% and an ongoing charge of 0.79% a year.
Artemis US Select Acc GBP (BMMV510) is steered by Cormac Weldon who has been investing in US equities for over two decades and Chris Kent. A team of sector analysts supports them.
The team conduct fundamental analysis to identify stocks which have more growth potential than inherent risk. The £1.6 billion fund has an ongoing charge of 0.85%. [MG]
If you believe many people, not much. The UK has been cast as the poor relation to other major stock markets thanks to a dreary performance in recent years; for example, the S&P 500 and Euro Stoxx 50 are up 40% and 30% respectively over the past three years, versus 19% for the FTSE 100.
But such an observation is a little unfair given the scale of income stocks that dominate the UK market. The FTSE 100 currently implies a 3.77% forward yield, which alone implies investors could be two-thirds of the way towards a long-run average total return of about 6%.
It’s also worth noting the global exposure of the UK market, where roughly 70% and 50% of
revenues are earned outside of the UK for the FTSE 100 and FTSE 250 respectively. That’s instant geographic diversification.
Sticky as a spider’s web inflation remains the big challenge, making us all feel poorer and meaning interest rates are likely to stay high for longer, upping the cost of capital for business and stretching mortgage repayments for millions.
This is not a forum for political debate but it’s fair to say Brexit has not helped matters, creating supply chain chaos and, arguably, feeding rising prices. This said, analysts see demand remaining supportive and the overall UK economy remaining resilient.

highly popular Vanguard FTSE 100 (VUKE), which carries a 3.8% income yield, or iShares Core FTSE 100 (ISF).
Many investors perceive better growth opportunities among UK mid-cap, or FTSE 250 constituents. Investors are well- served here too; the Vanguard FTSE 250, which can be bought via income paying stock (VMID), or have dividends ploughed back into the fund (VMIG).
The Evenlode Income Fund (BD0B7C4) and BlackRock Throgmorton (THRG) investment trust are two popular ways to invest in UK stocks. They share many of the same characteristics, seeking to run a high-conviction portfolio of high quality, financially strong, highly profitable and cash generative companies, typically with a growth tilt.
But there is a key difference, where two-thirds of the former’s assets are drawn from the FTSE 100, the BlackRock trust hunts for opportunities among smaller UK companies, including AIM-quoted stocks like Gamma Communications (GAMA:AIM), CVS (CVS:AIM) and 4imprint (FOUR), the FTSE 250 promotional products supplier. [SF]
From a stock market standpoint, relative value in the UK is seeding M&A activity, creating opportunities for investors. But for UK markets to reverse years of underperformance versus peer indices, more growth companies will be needed to attract investors’ interest, especially from overseas. FTSE 100 annualised 10year
Table: Shares magazine • Source: Morningstar
Worth about 85% of the UK stock market, the FTSE 100 is not only the nation’s equity benchmark, but it also makes it by far its most influential index and is treated as the lead indicator of the mood of UK share buyers and sellers. There are countless inexpensive ETFs to track the FTSE 100, such as the
The conventional view of global markets is that the US is the best place to find growth and innovation while Europe is home to more stodgy, less dynamic businesses.
As Alan Ray at Kepler Partners puts it: ‘The US has long been exceptionally good at producing the types of companies that, given time and investment, can and do disrupt entire business models, or create entirely new ones. The US is simply good at that kind of stuff, and its equity
market often benefits as a result.’
Yet the fact is Europe can boast worldbeating companies of its own, from fashion to pharmaceuticals and semiconductor companies, and unlike many US firms which just focus on their domestic market European companies tend to sell their wares globally.
The problem for European companies is their valuations seldom match their US counterparts.
As Kepler’s Ray points out, the MSCI Europe index currently trades on 12 times forward earnings, has a price-to-book ratio of 1.8 times and yields 3.3%, while the MSCI US index is on 18.6 times forward earnings, has a price-to-book ratio of four times and yields just 1.6%.
The war in Ukraine and the resulting surge in energy prices saw investors withdraw around $100 billion from European equities last year, with much of that money reinvested in US stocks and bonds.
As well as the MSCI Europe index, individual country benchmarks which investors should watch are the German DAX 40, the French CAC 40 index, the Dutch AEX 25 index and the Swiss SMI index. Popular ETFs (exchange-traded funds) include the Lyxor Core Euro Stoxx 50 (MSED) and Lyxor Core Stoxx Europe 600 (MEUD) which carry an ongoing annual charge of just 0.07%.
Sam Morse, who has managed £1.5 billion Fidelity European Trust (FEV) for the last 12 years, looks for companies which are ‘built to stand the test of time’, meaning they can grow their dividends
as well as generating capital gains whatever the economic backdrop.
Christian Diebitsch, manager of the Heptagon European Focus Fund (BPT3468), has a different strategy, taking a high-conviction, bottom-up approach to invest in a small number of highquality businesses (typically between 20 and 30) with sustainable long-term growth purely for capital gains. [IC]


Japan has a wealth of high-tech and high-quality companies which are becoming increasingly shareholder friendly, returning more to investors through dividends and buybacks. This increased generosity is underpinned by extraordinarily strong balance sheets.
Weakness in the yen, driven by a looser monetary policy in Japan than in the West, is supporting exports which account for a sizeable proportion of GDP. The country is also benefiting, to some extent, from a reopening of the Chinese economy and an increase in regional tourism. Domestically increasing wages are helping to boost consumption.
Alongside a lot of lesser-known businesses which are nonetheless at the forefront of developments in areas like automation and robotics, Japan is also home to household names like Sony (6758:TYO), Nintendo (7974:TYO) and Toyota (7203:TYO).
One substantial risk for investors to consider is the robust performance of Japanese stocks so far this year and whether this could encourage a bout of profit taking as valuations become more stretched.
Currency is another potential hazard and investors should be aware this will affect their returns. A weak yen against sterling means UK-
based Japanese funds (priced into sterling) have not kept pace with the performance of underlying Japanese indices.
The main index to watch when tracking Japanese shares is the Nikkei 225, often shortened to Nikkei. This is a price-weighted index with the constituents reviewed annually. There are a decent number of exchange-traded funds tracking Japanese stocks, such as iShares Core MSCI Japan (SJPA) which has an ongoing charge of 0.15%.
A currency hedged tracker like UBS MSCI Japan UCITS ETF (hedged to GBP) (UB02) looks to balance out foreign exchange moves. Such products are typically more expensive with the UBS one charging 0.29% but such a product would have enabled you to better participate in Japan’s first-half 2023 rally.
M&G Japan (B74CQP7) has delivered an annualised total return of 9.1% over the past 10 years. A concentrated portfolio, it has a focus on both growth and value. Top holdings include Hitachi (6501:TYO), Sony and Honda Motor (7267:TYO). The ongoing charge is 0.55%.
A slightly different approach is pursued by Nippon Active Value Fund (NAVF) which looks to actively engage with companies in its portfolio to help drive improved performance and unlock value. Launched in February 2020, the trust has delivered a three-year annualised return of 14.8%. Ongoing charges are relatively high at 1.41% and reflect the extra work which goes into managing the fund. [TS]


Because they are at a different stage in their development, emerging markets tend to have greater growth potential than the developed world. This is further underpinned by their more youthful demographics, with larger working age populations.
These markets have typically moved on from the commodity drivers and sources of cheap labour and exports they were 20 or 30 years ago and now play host to some of the world’s most innovative companies. This includes the world leading chip maker, Taiwan Semiconductor Manufacturing Company (2330:TPE).
Beyond China (covered separately in this article) the emerging markets space is dominated by other Asian economies like India, Taiwan and South Korea. Valuations are undemanding relative to companies in the West and levels of debt are lower.


Emerging markets can be more volatile, currency devaluations are a fact of life and corporate governance standards can be behind those seen in most Western countries.
This is particularly the case in countries where ownership rights are not as well protected, perhaps because of a lack of separation between the judicial system and a country’s government.
The peaceful transfer of power is more of an issue in emerging markets with political instability something investors must watch.
The main regional indices are MSCI Emerging Markets and FTSE Emerging Markets. They have a key difference because FTSE classifies South Korea as a developed market.
Most ETFs track the MSCI Emerging Markets index, such as HSBC MSCI Emerging Markets (HMEF) which has an ongoing charge of 0.15%. It is possible to get emerging markets exposure excluding China through iShares MSCI EM ex-China (EXCS), with an ongoing charge of 0.18%.
A top quartile performing fund over three, five and 10 years, BNY Mellon Global Emerging Markets Opportunities (BVRZK93) has delivered a 10-year annualised return of 8%, with ongoing charges of 0.88%.
The fund has a high conviction and unconstrained approach, reflected in the fact India has the largest country weighting in the portfolio at 26.6% compared with 14.3% in the MSCI Emerging Markets index.
An investment trust with a much lower allocation
to China (1.7%) than the benchmark is Utilico Emerging Markets (UEM). Trading at a 15.3% discount to net asset value, the trust is focused on infrastructure investments. It has an ongoing charge of 1.19%. [TS]
China warrants an allocation in portfolios due to the stock market’s low equity ratings which leave a low bar for upside surprises, and the pent-up consumer demand being released after harsh lockdowns during the pandemic, with themes such as the consumer, green energy and digital spending expected to lead the recovery. High household savings should support domestic demand in populous China, which is likely to see more stimulus measures which would be supportive for equities following downward revisions to 2023 growth projections by major banks and credit agencies. After an economic rebound in the first quarter with GDP growth at 4.5% growth momentum has subsequently softened, prompting concerns about the longevity of the Chinese growth story.
China’s much-hyped economic restart is fading, with S&P Global having downgraded its GDP growth forecast for 2023 from 5.5% to 5.2%, while the near-term outlook for domestic consumption is clouded by weak consumer confidence with youth unemployment at a record high.
The property market is still subdued, while an additional risk is geopolitics, with fraught USChina relations a threat to growth. A considerable number of China’s companies also have many environmental, social and governance (ESG) issues to resolve.
The indices that matter for China include the Shanghai Stock Exchange (SSE) Composite Index, often called the SSI Index, which tracks all stocks traded on the Shanghai Stock Exchange, as well as the CSI 300, considered the bluechip benchmark for mainland China stock exchanges because it tracks both the Shanghai and the Shenzhen markets.
The MSCI China index is the one most products track. Investors seeking exposure could opt for Xtrackers MSCI China (XCX6) or HSBC MSCI China (HMCA), an ETF that replicates the performance of the MSCI China Index with a competitive ongoing cost of 0.3%.


The China-focused investment trust on the widest discount in the Association of Investment Companies’ (AIC) China/Greater China sector, Abrdn China (ACIC), which invests in onshore China companies and those with operations in China and is managed by Abrdn’s 13-member China team led by Nicholas Yeo.





The trust offers exposure to the likes of Tencent, beverages business Kweichow Moutai, online retailer Alibaba and pan-Asian life insurer AIA and reported a materially improved performance for the six-month period to 30 April.
In the funds universe, Matthews China Small Companies (BJN4L97) offers exposure to mid and small caps employing Matthews Asia’s bottom-up, fundamental investment philosophy, with top 10 positions ranging from China Overseas Property and Alchip Technologies to Yangzijiang Shipbuilding. [JC]

DISCLAIMER: Ian Conway owns units in Heptagon European Focus Fund. Steven Frazer and Ian Conway own units in Fundsmith Equity Fund.
Investors who don’t want single-country funds should explore the universe of global funds and trusts, which offer broad-based global exposure in one product. For example, the diversified F&C Investment Trust (FCIT) has 52.7% of its assets in North America, 13.5% in Europe, 8.9% in Emerging Markets, 6.9% in Japan and 10% in the UK, while Alliance Trust (ATST) is 57% invested in North America, 15.9% in Asia and Emerging Markets, 14.7% in Europe and 9.1% in the UK. In contrast, Brunner (BUT) is lighter on North America at 39.8% of assets, with greater exposure to the UK at 26.3% exposure, with 26.2% of the fund invested in Europe ex-UK and 5.7% in the Pacific ex-Japan region.
A 13% share price discount to NAV (net asset value) at investment trust Bankers (BNKR) presents a buying opportunity for those seeking a ‘one-stop shop’ for global equity exposure through six geographic portfolios or ‘sleeves’. The diversified trust holds the likes of Microsoft (MSFT:NASDAQ), Apple (AAPL:NASDAQ) and JPMorgan Chase (JPM:NYSE), Bankers has achieved 56 years of consecutive annual dividend growth.
Those seeking access to the stock picking acumen of Terry Smith should buy Fundsmith Equity (B41YBW7), the popular global fund benefiting from a return to form of quality growth. The fund is concentrated around a small number of high quality, resilient, global growth companies, with its 26 holdings including Meta Platforms (META:NASDAQ), LVMH (MC:EPA) and L’Oréal (OR:EPA). [JC]

Retail investors are being offered the chance to buy shares in a fundraising by a UK-listed mining outfit looking to produce metals for electric vehicles.
ACG Acquisition Company (ACG) was launched in October 2022 as a SPAC (special purpose acquisition company) otherwise known as a cash shell. These are listed vehicles which have no assets apart from cash and are set up with the intention to buy businesses or assets.
ACG has found what it wants to purchase, agreeing to pay $1 billion for two Brazilian mines. These are a nickel sulphide asset called Santa Rita, operated by a company called Atlantic Nickel, and a producing copper mine called Serrote. They are both currently owned by resources-focused private equity firm Appian Capital.
Once this deal complete ACG will change its name to ACG Electric Metals and it is looking to raise $301 million to help cover the costs of the deal from retail and institutional investors.
The remainder of the money is coming from some heavyweight backers like Glencore (GLEN), car maker Stellantis (STLA:NYSE) and specialist mining investor La Mancha, each of which have agreed to subscribe for $100 million, as well as a $100 million prepayment for production from Volkswagen’s (VOW3:ETR) battery venture PowerCo, some debt and a royalty agreement with Royal Gold (RGLD:NASDAQ).
The plan is for the nickel concentrate to be
refined at Glencore’s facilities in Europe and North America with the final product being incorporated into electric vehicle batteries by Stellantis, PowerCo and other manufacturers.
Retail investors have until 18 July to subscribe for the share offer. Though before they do there is some salient background to these assets and the whole venture which is worth considering.
The assets in question were in the process of being bought by South African mining giant Sibanye-Stillwater (SBSW:NYSE) before it pulled the plug on a $1 billion cash deal (with a 5% royalty on future output) in early 2022 thanks to a ‘geotechnical incident’ at Santa Rita, thought to be cracks which occurred during the open pit mining operation.
Appian disputed this was a major adverse event which justified cancelling the transaction and began legal proceedings for a $1.2 billion claim in the High Court in London. Atlantic Nickel is itself subject to litigation in Australia from Queensland’s Mining Standards International which previously tried to buy the Santa Rita mine.
ACG was set up by Artem Volynets, former CEO of small cap gold miner Chaarat Gold (CGH:AIM).
By Tom Sieber Deputy Editor

While economic uncertainty and jittery markets make for a challenging investment environment, for the discerning investor, they also create fantastic opportunities. Amid the turmoil, there are hidden gems, companies that are not only surviving but have become undervalued and are thriving. In such a market, stock picking is more important than ever.
The economic outlook, both globally and in the UK, remains deeply uncertain. The war in Ukraine grinds on, tensions between the West and China remain elevated, inflation remains stubbornly high and central banks around the world continue to raise interest rates.

Domestically, inflation in the UK has dropped back from its peak of more than 11% in August 2022, but it has not fallen as fast as many had hoped. As a result, the Bank of England has signalled that it will continue to raise interest rates, leading many to forecast a recession for the UK economy. This has sparked volatility in all corners of the market, making uncertainty the new normal.
In such an environment, being selective about your investments is key. At the Henderson Smaller Companies Investment Trust, we believe that true active management will navigate you through challenging periods. Yes, there are many economic risks and challenges, but not all companies are equally exposed, and some are extremely well-placed to thrive in current environment. Active management is all about selective discernment, shutting out the noise and finding the hidden gems amongst the volatility.
• The current market backdrop is ripe for stock pickers looking for hidden gems that have been caught in the recent sell-off and are being overlooked by the wider market.
• We look for companies that produce quality products, have a sustainable competitive advantage, a strong balance sheet, and ambitious and capable management that can navigate the business through challenging times.
• While there are many economic risks and challenges, not all companies are equally exposed, and some are extremely wellplaced to thrive and take market share from their competitors.
It is a strategy that has served us well. Total share price returns over the last 10 years are 142%, well above our benchmark and the FTSE All-Share Index.
The current economic and market environment is ripe for stock pickers looking for hidden gems that have been caught in the indiscriminate selloff we have experienced over the last few years and are being overlooked by the wider market. And there are certain qualities we look for in these businesses.

We look for strong franchises – quality products, loyal customers and a valuable brand are all essential if a company is to weather tough economic conditions and grow while other businesses struggle. A sustainable competitive advantage is also key – a company with a dominate or fast-growing market share, a strong unique proposition, patented intellectual property or some other factor that gives them an edge over rivals
Within these strong franchises, we also look for skilled management teams that can grow the business and can navigate challenging market environments. A strong management team will ensure that its goals and objectives are aligned with its long-term growth and can generate sustainable revenues.
Another crucial factor is a healthy balance sheet or strong financials. Interest rates may soon peak and begin to fall once again, but they are still likely to settle at a level far above the historic lows that have been typical for the last decade or more. Companies that have depended on cheap borrowing and have high debt levels will be at risk. Those with low levels of borrowing, cash
deposits or valuable tangible assets are not only less exposed to higher interest rates, but they also have the financial firepower to invest for growth. These criteria are the starting point. Detailed analysis and research are then essential to pick out those individual businesses that not only meet these core criteria, but which have that extra factor that makes them a hidden gem of value.
Our most successful investments in recent years include Watches of Switzerland, a leading retailer of luxury watches and jewellery in the UK and US. The group has a 40% share of the UK luxury watch market and 10%+ share of the US luxury watch market. Over 50% of revenues are generated from the sale of Rolex watches. In addition to driving sales densities across existing stores through improved marketing and stock availability, management’s growth strategy is centred around expansion in the US and Europe where there is significant potential for market share gains.
Another success has been Oxford Instruments, a manufacturer of scientific and technical equipment with significant sales in the healthcare and medical sectors. Oxford Instruments’ prominence in the Henderson Smaller Companies’ portfolio has grown steadily over the years and in recent months has become a top contributor to performance.
Over the last year, we have added several investments we see as undervalued opportunities including GlobalData, a data analytics and consulting company that provides unique data, expert analysis, and innovative solutions to companies in the world’s largest industries. Another addition has been Ergomed, a company dedicated to the provision of specialized services to the pharmaceutical industry and

the development of new drugs. It has provided clinical development, trial management, and pharmacovigilance services for 300+ clients, from top 10 pharmaceutical and generics organizations to small and mid-sized drug development companies. Meanwhile, we have also added Morgan Advanced Materials, a manufacturer of advanced ceramic and composite products used in industries from steel to electronics.
In the current uncertain economic environment,
stock picking is the key to maintaining a successful portfolio. Quality products, strong market positions, strong balance sheets and ambitious and capable management – these are the characteristics that deliver for investors. At Henderson Smaller Companies Investment Trust, we have been following this approach for years and have outperformed the market as a result. Today, in the wake of recent crises, many highquality smaller UK companies are significantly undervalued. It is an opportunity we do not intend to miss.
These are the views of the author at the time of publication and may differ from the views of other individuals/teams at Janus Henderson Investors. References made to individual securities do not constitute a recommendation to buy, sell or hold any security, investment strategy or market sector, and should not be assumed to be profitable. Janus Henderson Investors, its affiliated advisor, or its employees, may have a position in the securities mentioned.
Past performance does not predict future returns. The value of an investment and the income from it can fall as well as rise and you may not get back the amount originally invested.
The information in this article does not qualify as an investment recommendation.
Janus Henderson, Knowledge Shared, Knowledge Labs are trademarks of Janus Henderson Group plc or one of its subsidiaries. © Janus Henderson Group plc. GC-0123-121490

Please read the following important information regarding funds related to this article.
The Henderson Smaller Companies Investment Trust. Before investing in an investment trust referred to in this document, you should satisfy yourself as to its suitability and the risks involved, you may wish to consult a financial adviser. This is a marketing communication. Please refer to the AIFMD Disclosure document and Annual Report of the AIF before making any final investment decisions.
Balance sheet – A financial statement that summarises a company's assets, liabilities and shareholders' equity at a particular point in time. Each segment gives investors an idea as to what the company owns and owes, as well as the amount invested by shareholders. It is called a balance sheet because of the accounting equation: assets = liabilities + shareholders’ equity.
Volatility – The rate and extent at which the price of a portfolio, security or index, moves up and down. If the price swings up and down with large movements, it has high volatility. If the price moves more slowly and to a lesser extent, it has lower volatility. Higher volatility means the higher the risk of the investment.
• If a Company's portfolio is concentrated towards a particular country or geographical region, the investment carries greater risk than a portfolio that is diversified across more countries.
• Most of the investments in this portfolio are in smaller companies shares. They may be more difficult to buy and sell, and their share prices may fluctuate more than those of larger companies.
• This Company is suitable to be used as one component of several within a diversified investment portfolio. Investors should consider carefully the proportion of their portfolio invested in this Company.
• Active management techniques that have worked well in normal market conditions could prove ineffective or negative for performance at other times.
• The Company could lose money if a counterparty with which it trades becomes unwilling or unable to meet its obligations to the Company.
• Shares can lose value rapidly, and typically involve higher risks than bonds or money market instruments. The value of your investment may fall as a result.
• The return on your investment is directly related to the prevailing market price of the Company's shares, which will trade at a varying discount (or premium) relative to the value of the underlying assets of the Company. As a result, losses (or gains) may be higher or lower than those of the Company's assets.
• The Company may use gearing (borrowing to invest) as part of its investment strategy. If the Company utilises its ability to gear, the profits and losses incurred by the Company can be greater than those of a Company that does not use gearing.
• Using derivatives exposes the Company to risks different from - and potentially greater thanthe risks associated with investing directly in securities. It may therefore result in additional loss, which could be significantly greater than the cost of the derivative.
References made to individual securities do not constitute a recommendation to buy, sell or hold any security, investment strategy or market sector, and should not be assumed to be profitable. Janus Henderson Investors, its affiliated advisor, or its employees, may have a position in the securities mentioned.
Not for onward distribution. Before investing in an investment trust referred to in this document, you should satisfy yourself as to its suitability and the risks involved, you may wish to consult a financial adviser. This is a marketing communication. Please refer to the AIFMD Disclosure document and Annual Report of the AIF before making any final investment decisions. Past performance does not predict future returns. The value of an investment and the income from it can fall as well as rise and you may not get back the amount originally invested. Tax assumptions and reliefs depend upon an investor’s particular circumstances and may change if those circumstances or the law change. Nothing in this document is intended to or should be construed as advice. This document is not a recommendation to sell or purchase any investment. It does not form part of any contract for the sale or purchase of any investment. We may record telephone calls for our mutual protection, to improve customer service and for regulatory record keeping purposes.
Issued in the UK by Janus Henderson Investors. Janus Henderson Investors is the name under which investment products and services are provided by Janus Henderson Investors International Limited (reg no. 3594615), Janus Henderson Investors UK Limited (reg. no. 906355), Janus Henderson Fund Management UK Limited (reg. no. 2678531), (each registered in England and Wales at 201 Bishopsgate, London EC2M 3AE and regulated by the Financial Conduct Authority) and Janus Henderson Investors Europe S.A. (reg no. B22848 at 2 Rue de Bitbourg, L-1273, Luxembourg and regulated by the Commission de Surveillance du Secteur Financier).
Janus Henderson and Knowledge Shared are trademarks of Janus Henderson Group plc or one of its subsidiaries. © Janus Henderson Group plc


Effectively tangible book value represents what shareholders could expect to receive if a company goes bankrupt and this forces the liquidation or sale of its physical assets (things like property and equipment).
With AI (artificial intelligence) the flavour of the month and investors focused on intangible assets such intellectual property and brand value, investors may be under valuing real, tangible assets lurking on balance sheets.
The value of tangible assets has been a major feature of recent mergers and acquisition activity in the automotive retailer market.
When Lookers (LOOK) received a knockout all-cash bid (20 June) from Canadian dealerships operator Alpha Auto the deal was struck at 35% premium to the prior closing price.
It became the latest quoted car retailer to be taken over, following on from successful takeovers of Marshall Motor and Cambria Automobiles along with Pendragon (PDG) which has also drawn bid interest. One the drivers of the deals seems to be the significant freehold property owned by the operators.
This article scours the UK market for companies where hard tangible assets represent a substantial chunk of enterprise value or the total value of a company including net debt.
It does not have to be freehold property backing, but hard assets in general. For example, mining and drilling equipment specialist Capital (CAPD) has approximately £200 million of plant and machinery on its balance sheet.
The enterprise value of the business is £205 million and net debt is low at £22 million. In other words, any acquirer would get the future profit stream from those assets almost for free. Historically, the profit and return on capital have been fairly good.
The business has generated an average 16% return on capital employed over the last five years and book value per share has grown at a compound annual growth rate of 18% a year.
An acquirer would need to pay a premium for control of the business but even so, the shares look vulnerable to a takeover. Another benefit of real assets is they tend to keep pace with inflation which provides a natural hedge against a general rise in prices.
Using Stockopedia software we have screened the UK market for companies with a high proportion of tangible assets to enterprise value and low debts.
Given merger activity in the sector it should as no surprise to find automotive retailer Vertu Motors (VTU:AIM) on the list. Net fixed tangible assets are around £400 million, roughly the same as enterprise value.
We highlighted Vertu Motors in an article in May 2022 at a price of 51p saying the Bristol Motors retailer looks too cheap for its highly cash
Investors often spend less time studying balance sheets but it can reveal hidden gems
generative business and strong property asset backing. The company has grown its book value by 7.6% a year over the last five years.

Supermarket Sainsbury’s (SBRY) has been targeted in the past for the value of its freehold property. Its largest shareholder Qatari Investment Authority fund made an unsuccessful takeover approach in 2007.
Private equity firms have also considered bids with plans to split the property portfolio from the operating company. The value of net property, plant and machinery on Sainsbury’s balance sheet is £13.5 billion which is greater than the £11.7 billion enterprise value of the group.
There are few things more tangible than houses. Housebuilders feature heavily on the list with many trading below tangible book value. Unlike examples discussed so far, the bulk of the value is in inventories which represent houses yet to be sold.
Bellway (BWY) has one of the lowest price to tangible assets ratio among the housebuilders implying the shares trade at a 30% discount.
Enterprise value is £2.1 billion (net cash of £300 million) while the value of inventories is £4.4 billion. Rising interest rates and the spiralling cost of mortgages explains the big discount to tangible asset value across the sector as demand softens and volumes fall.
Analysts at Moody’s predict UK house prices could fall 10% this year and double that if the economy enters recession which looks more likely with two-year UK bond yields breaching 5.5%, the highest since 2008.
After peaking at close to £37 in the spring of 2021 Bellway shares has lost half their value. During the global financial crisis, the shares dropped 70% from their peak.
This time around though the balance sheet is far healthier with net cash suggesting the business can weather a deep recession. During the last housing crisis, it was rumoured that some hedge funds were looking to invest in the beaten-up housebuilders to run them for the implied cash run-off.
The biggest risk with the strategy is that house prices fall steeply, cutting the profit implied in the stock of unsold houses. But the big discount to tangible book value provides a decent margin of safety.
29.7P
Pubs group Marston’s (MARS) has bounced back strongly from the pandemic and is continuing to perform with first half sales to 1 April up 10% and momentum continuing into the second half.

Yet the shares trade roughly where they were in March 2020 and at a 77% discount to tangible book value. While the shares did not meet our strict net debt to tangible assets threshold of 30%, strong cash generation, a focus on debt reduction and strong freehold property backing means they are very underappreciated.
Also, the book value is likely understated as demonstrated by the sale of non-core assets at a 39% premium during the first half and a further £50 million to £60 million of non-strategic disposals slated for the second half.
The freehold property estate is valued at £1.8 billion with £1.2 billion of net debt, implying £600 million of equity value compared with a £200 million market capitalisation. Fund manager Mark Wright at Momentum Global Investment highlights Marston’s share of its joint-venture with Carlsberg (CARL-B:CPH) could be worth around £250 million.
‘I strongly believe somebody will look to buy that remaining 40% ownership stake from Marston’s in the future. The entire pub estate should also be able to generate earnings before interest and tax of more than £170 million in the near future.
‘In my opinion, it is obvious that the shares are currently massively mispriced,’ said Wright.
By Martin Gamble Education Editor• Learn how the markets work
• Discover new investment opportunities

• Monitor stocks with watchlists
• Explore sectors and themes

• Spot interesting funds and investment trusts
• Build and manage portfolios
Shares’ investment writer Sabuhi Gard delves into her experiences with buying stocks through her SIPP
Ithink the legendary US investor Warren Buffett once said, ‘an investor must understand a company’s products and its business model before making an investment’ which loosely translates to ‘buy what you know’.
I tried to adopt this strategy when filling my SIPP (self-invested investment plan) in 2019 after combining several smaller pension pots from former employers.
I chose a mixture of shares, funds, and investment trusts. I included some mainstream selections like Lloyds Banking (LLOY), one of the most widely traded stocks on the FTSE 100, energy giant Shell (SHELL) and Lindsell Train UK Equity (B18B9X7)
Over the past three years their performance has been mixed. Lindsell Train UK Equity has returned 17.5% on a cumulative performance basis, versus its IA UK All Companies benchmark’s 23.9%, so underperforming its benchmark slightly.
Shell’s shares have delivered a 100% total return, whereas Lloyds has delivered 56.1% over the same period. C’est la vie; no investor is perfect.
However, when I decided to expand my SIPP portfolio with some more ‘blue sky’ investment choices, I faced hefty losses.
Knowing what I know now about the companies I invested in, I probably wouldn’t have invested in Ocado (OCDO), Hipgnosis Songs Fund (SONG), Seraphim Space Investment Trust (SSIT) and Audioboom (BOOM:AIM)
I invested in online grocer Ocado because at the time I regularly shopped at Ocado and thought their service was great, but when Marks & Spencer (MKS) became joint owners of Ocado Retail in August 2019, I had my doubts as M&S products were less affordable than basic range products at Waitrose – Ocado’s previous supplier. Then the Covid-19 pandemic happened.
Consumers switched to online shopping in their thousands due to successive lockdowns and Ocado shares hit a peak of £28 on 5 February 2021 – I didn’t sell as I thought it was a great growth stock for my SIPP.
Yet disappointment over Ocado’s failure to execute on its opportunity of selling an outof-the-box online groceries solution to global supermarkets and a post-pandemic reversal in the trend towards a web-based weekly shop saw the shares hit a low of 358p on 2 June this year.
Both the Hipgnosis Songs Fund and Seraphim Investment Trust were ‘lockdown’ purchases. Most people opt to buy a cat or a dog, I opted to buy some ill-performing investments. Anyone who knows me, knows I’m a big music fan so I was intrigued by Hipgnosis – a music royalties and song management business founded by Merck Mercuriadis and legendary music producer Nile Rodgers. Slightly late to the party by two years (it was founded in 2018) I made my small investment in August 2020 just after an upbeat trading update (for the financial year ending 31 March 2020).
The company said: ‘Revenues from its catalogue were £64.7 million, ahead of expectations. Cash receipts from royalty statements [were] on average 2% higher-than-expected at the time of catalogue acquisitions.’
Besides this upbeat trading update, the company had recently bought Bon Jovi’s Richie Sambora music catalogue which included hit songs like You Give Love a Bad Name, Livin’ on a Prayer, Wanted Dead or Alive.
Despite the fund buying numerous music catalogues from well-known artists like Justin Bieber (a recent $200 million deal) Neil Young, Red Hot Chili Peppers, Chrissie Hynde, the FTSE 250 company and former media darling has failed to ignite investor interest – its shares are down 8% year-to-date and 42% since I first bought them. Part of the problem has been the dilution to existing shareholders from regular share issues to buy new catalogues.
Space investment trust Seraphim combined two of my interests: space and new issues on the stock market. So, when its shiny new online prospectus dropped into my inbox on 24 June 2021, I decided to ‘fill my boots’. It was coming to the market at a price of 100p with a £250 million price tag and it was hoping to raise another £150 million from its float. Seraphim was hoping to cash in (like myself) on the booming space industry.
All the billionaires were at it, including Tesla (TESLA:NASDAQ) founder Elon Musk, Amazon’s (AMZN:NASDAQ) Jeff Bezos and Richard Branson.
for the long-term Regularly
Invest
What a difference two years make. Branson’s satellite spin-off Virgin Orbit (VORB:NASDAQ) has shut down after a failed space mission and Seraphim’s shares are down nearly 80%. Investors have fallen out of love with these ‘blue sky’ investments, promising jam tomorrow, against a tough macroeconomic backdrop with rising inflation, interest rates and a mini-banking crisis at the end of 2022 and the start of 2023.
Mark Boggett CEO and co-founder of the trust, however, was upbeat when I interviewed him straight after reporting a disappointing set of results in March 2023.
He said: ‘Existing and potential investors should take strength from the fact that the company remains well-capitalised with cash reserves of £40.9 million.’
My cash reserves have been sadly depleted. Lessons have been learned with these more experimental investments for my SIPP but they are only a few of my selections which are part of a wider portfolio of more ‘balanced’ investment choices.
If I had my time again, I would have stuck to a ‘buy what you know’ as opposed to a ‘buy what you like’ strategy as a lot of my investing at the time was based on emotional choices. I would also take more time to consider the wider market context.

Since the pandemic we have become increasingly used to interacting online. Work Teams or Zoom meetings have become a regular occurrence for office workers and video conferencing obviously served a social function when Covid restrictions were in place.
Perhaps it’s not surprising then that Marks & Spencer’s (MKS) eye-catching ‘Share Your Voice’ campaign to push for a greater voice for ordinary shareholders presented online-only AGMs as a solution.

Marks’ own AGM this year was a digital-only affair, in a continuation of the enforced move online during Covid.
To give Marks & Spencer and its chairman Archie Norman their due, it is a really good thing they are pushing for retail investors to have more of a voice at the table. As the company says: ‘Outdated legislation means that ordinary people who have invested in the UK’s listed businesses struggle to hear from and communicate with them.’ You can read more about Marks’ campaign in this article.
Questioning directors in person at a AGM can be really rewarding for shareholders passing of a proposal for digital only AGMs would restrict shareholders’ ability to engage with company directors?”

Only ‘members’ of the company listed on the share register are ensured of the right to attend general meetings and vote on resolutions. To guarantee you are listed on the register you must hold your shares in paper certificate form or via a broker-sponsored Crest personal membership stockbroking account; Crest being the depository for the UK’s electronic share holdings.
If you instead hold shares in the nominee account of an investment platform, as most of us do, then your name is not on the register (the platform’s is instead) and nor are you a member, you are simply a beneficial owner of the shares.
That said, most platforms facilitate attendance at AGMs and enable investors to vote.
While the proposal for online-only AGMs might help in terms of accessibility, some see problems with this approach and some of the campaign’s other proposed solutions.
Social venture The Engagement Group (TEA for short) – which is set up to push for more inclusive investor engagement says: ‘How can shareholders and other stakeholders be assured that the Share Your Voice campaign’s headline call for shareholder democracy matches its motives, given that the passing of a proposal for digital only AGMs would restrict shareholders’ ability to engage with company directors?’
Another bugbear for TEA is that Share Your Voice’s proposals ‘pass on the responsibility of facilitating dialogue between companies and their ultimate shareholders to the platforms and the registrars, thereby removing responsibility from the company, which as described above can be fulfilled more easily and less expensively than what companies may initially think’.
TEA highlights the efforts of investment trust BlackRock World Mining (BRWM) to identify the names of the individual shareholders behind the nominee accounts and write to them individually to invite them to attend AGMs. As the TEA argues, a hybrid approach seems the most sensible option with in-person access facilitated alongside the ability to participate online. From this writer’s experience chairing Shares’ own Spotlight investor events, being able to get up close and personal with company directors and questioning them directly can be an extremely enlightening experience for ordinary investors.


This one number could have a big impact on stocks, bonds and commodities
With celebrations for the US Independence Day holiday of 4 July just dying down, it feels an appropriate time to revisit the US equity market. The timing fees particularly opportune as the S&P 500 is now in a new bull market, at least if you use the definition of a 20% gain from the last major low.
The American equity index bottomed at 3,577 and, at the time of writing, has subsequently advanced to 4,797, for a near-25% advance. The benchmark has achieved this despite, rising bond
yields, the latest debt ceiling drama and worries over a possible recession. Even a surge in the US Federal Funds rate from 0.25% to 5.25% is, so far, proving unable to stop American equities’ latest surge.
Easy on the eye as the chart for the S&P 500
Source: Refinitiv data
may be – at least for those investors with a sizeable weighting toward US equities and for those hedge funds who are not short the index – there is another trend to which attention must be paid. That is the yield on the benchmark US 10-year treasury, or government bond.



It is fast-approaching the March high of 4.07% and while this column has no pretensions to, or qualifications for, being a chartist, or technical analyst, the wedge shape of falling highs and rising lows that is forming suggests the 10-year yield is about to break out, possibly in a violent way.


A downward break – because the Fed, the market, or both – think inflation is under control could be seen as a good thing for American stocks, not least as it would help to justify the prevailing ‘Goldilocks’ narrative. After spending most of 2022 pricing in a recession, US equities are returning to a favourite theme, namely that the American economy will continue to grow, but not so fast as to force severe interest rises or prevent inflation from gently receding.
Whether the prospect of ‘no landing,’ rather than a ‘hard’ or ‘soft’ one, is credible is something that investors can only decide for themselves (even if such talk was prevalent in 1999 after a series of Fed rate hikes, only to ultimately prove inaccurate). It may be that the impact of the Inflation Reduction Act and Chips Act is still being felt in a construction and infrastructure boom that only starts to fade out in 2024, with the result that the US economy continues to defy the doubters.
One possible danger to this scenario is that the 10year treasury yield breaks out higher, as US growth does prove resilient, but so resilient that
USequities keep rising but the 10-year treasury yield is on the march as well The long-term relationship between oil and US 10-year yields is breaking down Source: Refinitiv data

supply of labour and materials, goods and services, struggles to meet demand, with the result that inflation stays above the Fed’s 2% target for some time to come.
The trend in the 10-year treasury is therefore one which investors should bear in mind, and it is one that will have implications for not just equities and bonds. Other asset classes will be watching closely as well, notably oil. While the past is no guarantee for the future, the price of crude seems to carry some correlation to the US 10-year yield. This makes sense in that oil can be a driver of inflation if prices rise and disinflation is the cost of a barrel declines, even if correlation does not necessarily mean causation.
This is particularly interesting at the moment because there is an unusual degree of divergence between the price of West Texas Intermediate and the benchmark US treasury yield. Oil is pricing in a recession it seems, treasuries may be pricing in persistent inflation and US equities look to be in ‘Goldilocks’ mode and looking solid growth and

cooling inflation.
They cannot all be right. US equities have done well, and oil stocks have not so perhaps if there is a surprise to come that may be the source. Although the dataset is not as long as would be ideal, but since 2001 the S&P 500 Integrated Oil & Gas sector’s market capitalisation has averaged 4.6% of that index’s total price tag.
Today that figure stands at just 2%. This may reflect the long-term plan to move toward greener, renewable alternatives and away from hydrocarbons, with all of the negative implications that has for demand for oil and gas, and also short-term demand worries. But if oil prices prove firmer than expected, and demand stronger for expected for longer than expected, oil stocks could yet confound the bears, even if investors who run strict environmental, social and governance (ESG) screens will be unmoved.
By Russ Mould Investment Director at AJ Bell


Aldo Boitano, CEO & Steve Kesler, Executive Chairman
CleanTech Lithium proudly sustainable, committed to net-zero. Our mission is to produce carbon-neutral lithium for the Electric Vehicle (EV) future. With proven sustainable Direct Lithium Extraction technology, powered by clean energy, we plan to be the leading supplier of green lithium to the EV market.

Steven Cooklin, CEO
Manolete Partners is a specialist insolvency litigation financing company. We fund or buy insolvency claims. We work with Insolvency Practitioners and their lawyers to maximise returns to creditors.
Paul Baay, CEO
Touchstone Exploration is a Canadian-based upstream oil and gas exploration and production company currently active in the Republic of Trinidad and Tobago. It is an independent onshore oil producer in Trinidad.

High street banks stand accused of short-changing savers by not passing on the full interest rate rise since the Bank of England hiked rates. Now the Government, regulators and news sites are all focused on the gap between what banks are charging on mortgage rates and what they are offering cash savers.
Moneyfacts data shows the gap is huge, with average two-year fixed rate mortgage going from 2.52% in June 2018 to 5.49% in June this year. At the same time average easy-access rates have only gone from 0.5% in 2018 up to 2.21% in June this year. Clearly shopping around can net you far higher savings rates, but there are lots of other ways to get money out of banks to boost your finances.
More people are shifting to fixed rate accounts as they are offering much higher rates than their easy-access counterparts. You need to be certain you will not need the money during the fix as often you will pay a penalty to withdraw the money early, or in some cases any access will be prohibited altogether.

But for a one-year fix you can get up to 6.05%, so it is worth considering. On £10,000 of savings the difference between the top-easy access rate (4.35%) and the top one-year fix equals £170 –so it is worth the tie-up if you know you will not need the money.
POTENTIAL BOOST: £170

Banks really want current account customers, even if they are not as fussed about getting savings customers. This means lots of them will offer a juicy bonus rate if you move your current account. It used to be quite a lot of hassle to move current accounts, but the Current Account Switching Service now takes care of the admin and will automatically transfer your accounts, balances and direct debits.
The top deal now is from NatWest, which will pay you £200 to move your account, while First Direct will pay you £175 and Lloyds will pay £150 plus a free reward (which includes cinema tickets or Disney+ subscription). You need to check the small print on all these deals before you switch – most won’t allow you to have been a customer of that bank or a sister bank in the past few years, they will also require you to pay in a certain amount of money within a couple of months of opening the account and many stipulate that you open the account online, rather than in branch.
POTENTIAL BOOST: £200

This was a widespread practice back when savings rates were high but it is died out since interest rates have been rock bottom. Despite the weird-sounding name it is remarkably simple: you do all your spending on a 0% credit card and instead divert your money to savings, netting you a decent interest.
There are some big health warnings here: you shouldn’t do this if you have worries about getting into debt or spending excessively when using a credit card, you should also make sure you have a good credit rating, you should be very clear on when you need to repay your credit card debt and you should always make the minimum payments.
Currently you can get a 0% credit card for up to 23 months, from both Natwest and Barclaycard (note: only those with the best credit ratings will get this, otherwise you will be offered a shorter period). So, if you spent £1,000 a month on that credit card and then diverted that £1,000 each month to your savings, earning the current top rate for an easy-access account of 4.35%, you would earn £287 on your money over a year. Obviously the higher your usual spending, the higher your potential savings interest.

You could also use a regular savings account and get a higher interest rate, but they will cap the amount you can put in each month (more on this later) – so a big spender would need to split their money between this and a standard easy-access account.
Regular savings accounts offer higher rates than easy-access accounts but they are much more limited on how much you can pay in each month. For example, the top account, from Skipton Building Society, pays 7.5% but only on up to £250 a month. This is great if you are genuinely saving money each month, but you should not use it for existing savings, unless you have already moved those savings to the top easy-access account. That is because you will only get the full 7% interest on the first monthly saving and get 11 months of that rate on the second month etc. until your final payment just gets one month at that 7% rate. For example, if you save the maximum £250 a month in that Skipton account, you will get £121 of interest across the year. On the £3,000 you have saved over that period that is an overall interest rate of 4%.

Lots of the best deals are for existing customers (the Skipton deal is one example), so you will either need to switch accounts (see above) or hunt out the best deal your bank offers. Before signing up you should check whether early withdrawals are allowed or whether you will face a penalty for withdrawing your money.

Our expert aims to help someone looking to boost their state pension entitlement

for lower NI contributions, employees agreed to opt-out of the ‘additional state pension’, meaning they would not build up an entitlement towards it. The additional state pension was part of the old state pension system which topped up your basic state pension entitlement.

Both contracting-out and the additional state pension were abolished from 6 April 2016, when the new flat-rate state pension was introduced. For those reaching state pension age after 5 April 2016, any years you contracted-out are deducted from your state pension entitlement when figuring out you ‘foundation amount’.
This means that even people with a NI contribution record of 35 years or more – the number you usually need to qualify for the full £10,600 a year new state pension – could be entitled to less than the full state pension amount if they contracted-out for several years under the old system.
I am a retired teacher and as a result get a reduced state pension because I was ‘contracted-out’. My date of birth is 23 August 1953.
I paid National Insurance (NI) for 46 years with no gaps but obviously paid at a reduced rate during the contracted-out period. Even though there are no gaps in my NI record, can I top up my NI contributions to boost my state pension entitlement?
I have tried contacting the Future Pension Centre but there are no options on their message system to press to answer this question.
Any guidance you can provide will be much appreciated.
CynthiaTom Selby, AJ Bell Head of Retirement Policy, says:
Contracting-out was an option previously open to people prior to 6 April 2016 whereby, in exchange
Anyone in this position can buy extra NI years from the government to boost their state pension entitlement. You usually need to pay voluntary ‘Class 3’ NI contributions to top up your state pension entitlement.
Normally, you can go back up to seven years to plug gaps in your NI record – meaning someone paying voluntary NI today would be able to buy NI for missing years going back to 6 April 2016.
However, transitional measures introduced as part of the 2016 state pension reforms mean you can go all the way back to 6 April 2006 to fill NI gaps. The Department for Work and Pensions (DWP) has recently extended the deadline for taking advantage of these transitional measures to 5 April 2025.
The Department for Work and Pensions (DWP) says anyone topping up for these periods will be charged 2022/23 Class 3 NI rates. It costs £15.85 to buy one week’s worth of Class 3 NI at those rates or £824.20 per year.
Based on someone increasing their entitlement


to the ‘new’ state pension (worth £203.85 per week in 2023/24), that could result in an income boost of £5.82 per week or £302.86 per year.
What’s more, that income will be protected by the ‘triple-lock’, meaning it rises every year by the highest of average earnings, inflation or 2.5%. In April this year, the state pension increased by a whopping 10.1%, in line with inflation in September 2022. Broadly speaking, anyone who increases their state pension on these terms will need to live three to four years to be in ‘profit’ from the deal.
Given average life expectancy at state pension age is around nine years for men and 11 years for women – with a decent chance of living into your 90s – those in good health who can boost their state pension could benefit handsomely by doing so.



However, not everyone who has previously contracted-out will benefit from paying voluntary NI. This is quite complicated and will depend on what you would have been entitled to under the old system.
As you are over state pension age, the DWP says you should contact the Pension Service to confirm if paying voluntary NI will boost your entitlement.
For anyone below state pension age, contact the Future Pension Centre to find out if paying voluntary NI will increase your entitlement.
It is worth making the effort to do this, as if you pay voluntary NI and don’t increase your entitlement, there is no guarantee you will get a refund.
EDITOR: Daniel Coatsworth @Dan_Coatsworth
DEPUTY EDITOR: Tom Sieber @SharesMagTom
NEWS EDITOR: Steven Frazer @SharesMagSteve
FUNDS AND INVESTMENT
TRUSTS EDITOR: James Crux @SharesMagJames
EDUCATION EDITOR: Martin Gamble @Chilligg
COMPANIES EDITOR: Ian Conway @SharesMagIan
INVESTMENT WRITER: Sabuhi Gard @sharesmagsabuhi
CONTRIBUTORS:
Danni Hewson
Laith Khalaf
Russ Mould
Tom Selby
Laura Suter
Shares magazine is published weekly every Thursday (50 times per year) by AJ Bell Media Limited, 49 Southwark Bridge Road, London, SE1 9HH. Company Registration No: 3733852.
All Shares material is copyright. Reproduction in whole or part is not permitted without written permission from the editor.
Shares publishes information and ideas which are of interest to investors. It does not provide advice in relation to investments or any other financial matters. Comments published in Shares must not be relied upon by readers when they make their investment decisions. Investors who require advice should consult a properly qualified independent adviser. Shares, its staff and AJ Bell Media Limited do not, under any circumstances, accept liability for losses suffered by readers as a result of their investment decisions.
Members of staff of Shares may hold shares in companies mentioned in the magazine. This could create a conflict of interests. Where such a conflict exists it will be disclosed. Shares adheres to a strict code of conduct for reporters, as set out below.
1. In keeping with the existing practice, reporters who intend to write about any securities, derivatives or positions with spread betting organisations that they have an interest in should first clear their writing with the editor. If the editor agrees that the
reporter can write about the interest, it should be disclosed to readers at the end of the story. Holdings by third parties including families, trusts, selfselect pension funds, self select ISAs and PEPs and nominee accounts are included in such interests.
2. Reporters will inform the editor on any occasion that they transact shares, derivatives or spread betting positions. This will overcome situations when the interests they are considering might conflict with reports by other writers in the magazine. This notification should be confirmed by e-mail.
3. Reporters are required to hold a full personal interest register. The whereabouts of this register should be revealed to the editor.
4. A reporter should not have made a transaction of shares, derivatives or spread betting positions for 30 days before the publication of an article that mentions such interest. Reporters who have an interest in a company they have written about should not transact the shares within 30 days after the on-sale date of the magazine.